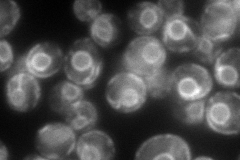
YJR143C
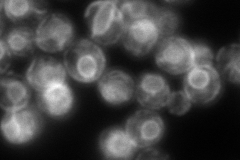
YJR143C
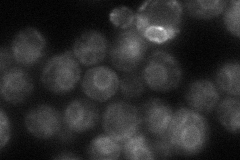
YJR143C
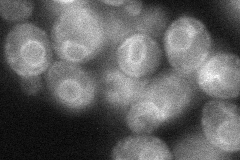
YJR143C

View description
Protein O-mannosyltransferase, transfers mannose residues from dolichyl phosphate-D-mannose to protein serine/threonine residues; appears to form homodimers in vivo and does not complex with other Pmt proteins; target for new antifungals
Localization:
Intensity:
Fold change:
Significance:
-
C’ GFP library in SD

ER19.95 -
N' NOP1pr-GFP in SD
ER162.484 -
N' TEF2pr-mCherry in SD
ER259.472 -
N' NATIVEpr-GFP in SD
ER46.1247 -
N' TEF2pr-VC and Cyto-VN in SD
ER47.3151 -
C’ GFP library in SD+DTT

ER16.330.81No -
C’ GFP library in SD+H2O2

ER17.650.88No -
C’ GFP library in Starvation Media

ER16.760.84No -
C’ GFP library on the background of Pup2-DaMP

ER -
C’ GFP library on the background of CCT mutant

ER16.37890.820826No
